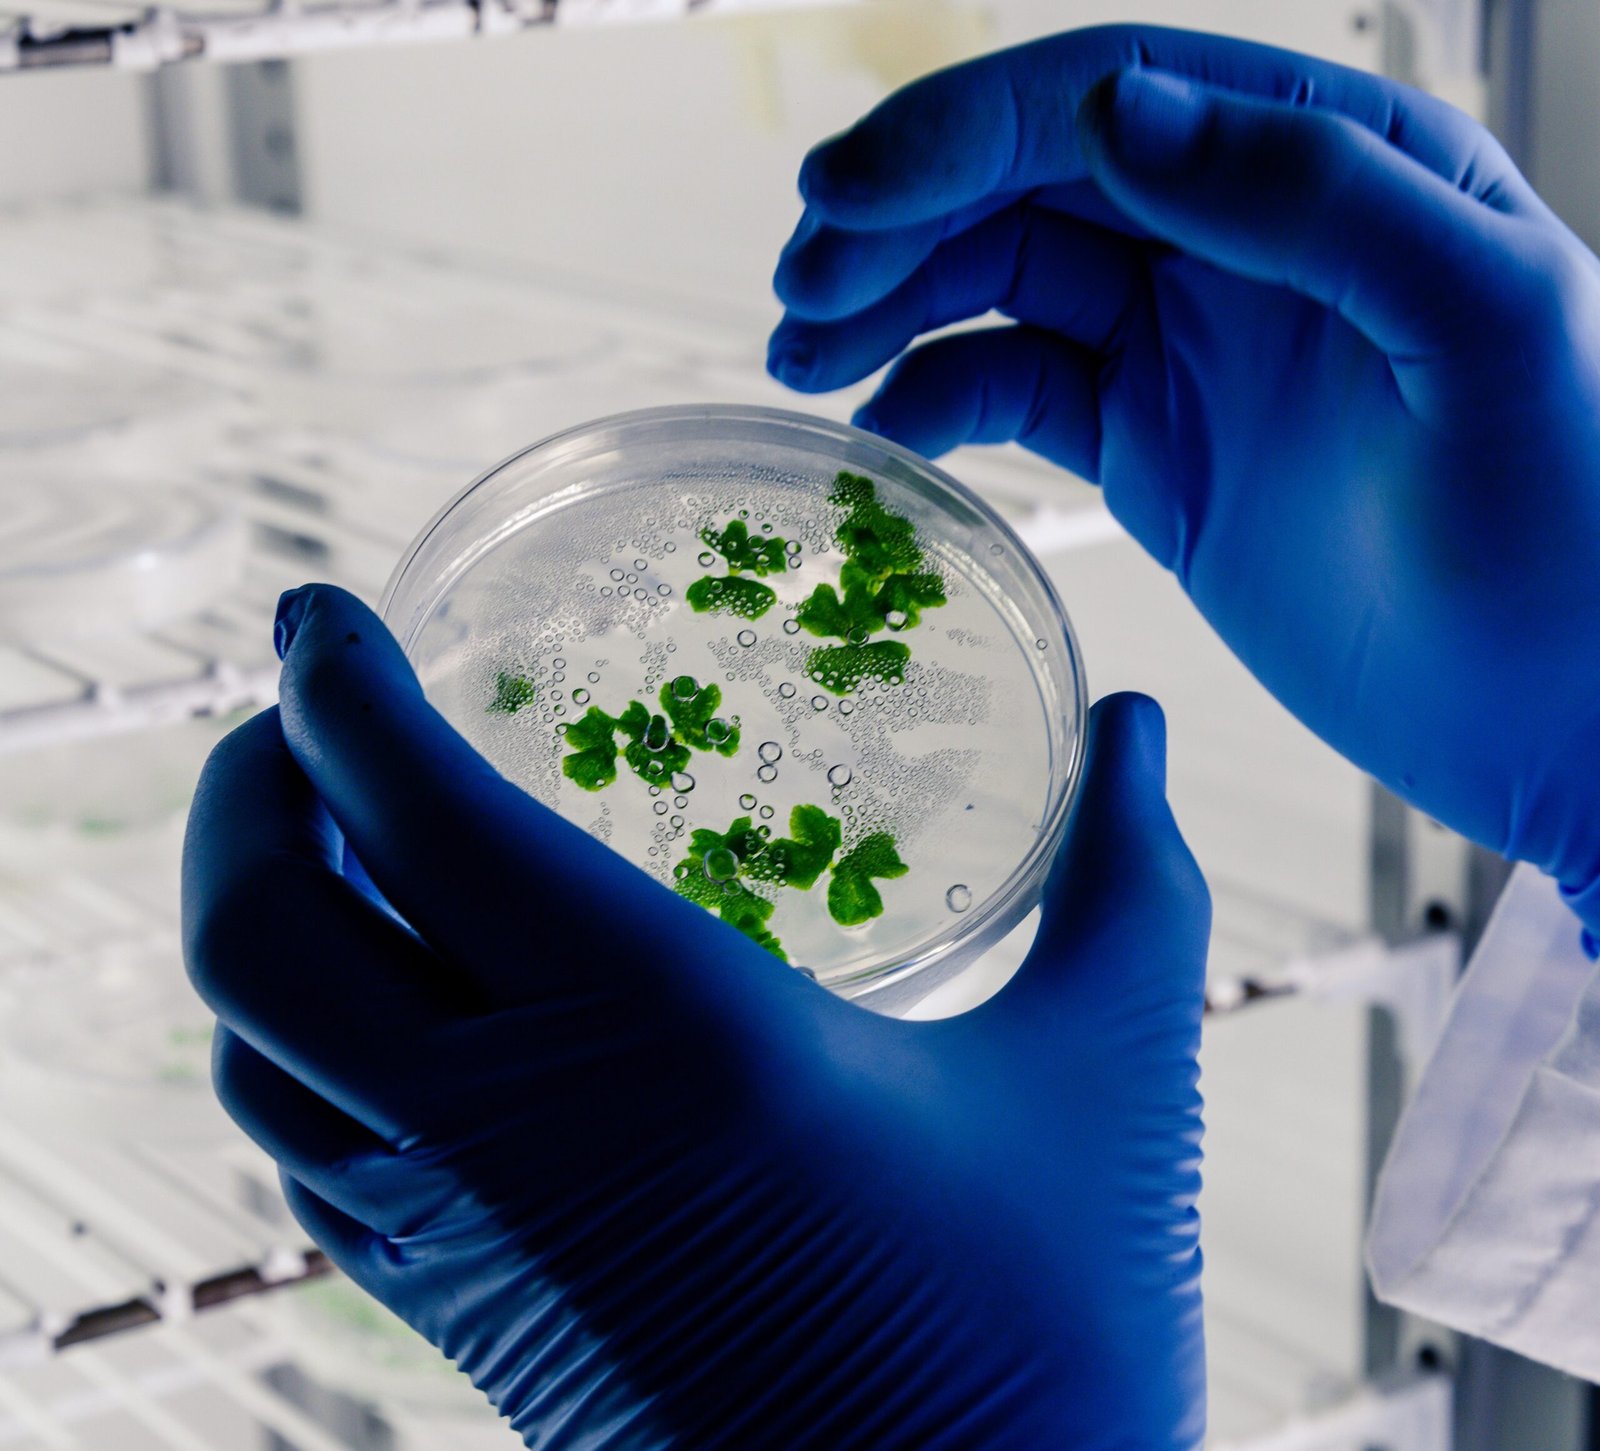

Alineación con el Currículum Nacional de Biología Celular y Molecular:
✔ Unidad 2: Dogma Central de la Biología Molecular
- OA 3: Analizar cómo la información genética fluye desde el ADN hasta las proteínas.
- Relación: El kit permite identificar diferencias genéticas en el gen SBE1, observando cómo una mutación afecta la expresión de un rasgo.
✔ Unidad 3: Regulación y Expresión Génica
- OA 4: Explicar cómo las variaciones en el ADN afectan la herencia de los caracteres en organismos.
- Relación: Se analiza la transmisión mendeliana de alelos dominantes y recesivos mediante la electroforesis en gel.
- OA e: Construir y comunicar argumentos científicos a partir de la evidencia experimental.
- Relación: Los estudiantes interpretan los resultados de la electroforesis y relacionan el genotipo con el fenotipo.
✔ Unidad 4: Aplicaciones en Biotecnología
- OA 6: Evaluar cómo el conocimiento en genética y biotecnología ha impactado la sociedad.
- Relación: El experimento permite comprender los principios básicos de la genética aplicada a la biotecnología y evolución.
✔ Habilidades Científicas Desarrolladas
- Uso de micropipetas y manipulación de muestras.
- Electroforesis en gel para analizar variabilidad genética.
- Interpretación de resultados para determinar genotipos.
- Uso del método científico en experimentación genética.
Técnicas: Micropipeteo, Electroforesis en gel
Temática: De genotipo a fenotipo, Herencia mendeliana, Biotecnología
Nivel: Escuela secundaria general, Secundaria básica
Tiempo requerido: 45 minutos
INCLUYE:
Este kit de laboratorio proporciona suficientes reactivos para ocho grupos de laboratorio:
- Una introducción atractiva y accesible a la electroforesis en gel.
- Tintes seguros y no tóxicos que son directamente visibles sin necesidad de teñir el gel.
- Muestras prealicuotadas y tabletas de agarosa premedidas para facilitar la preparación.
- Reactivos para electroforesis en gel incluidos: buffer para electroforesis TBE y 8 Agarose Tabs™.
- Compatible con los sistemas de electroforesis Bandit™, blueGel™ y sistemas tradicionales de electroforesis en gel.
- Un punto de partida económico para explorar la biotecnología y la genética.
- 8 Load Ready™ Strips (tiras de tubos que contienen muestras de tinte prealicuotadas)
- 8 Agarose Tabs™
- Buffer para electroforesis TBE, en polvo para hacer 600 ml
ALMACENAR:
Los reactivos son estables durante 12 meses cuando se almacenan a temperatura ambiente.
REQUIERE:
Equipo requerido:
- Micropipetas de volumen variable de 2-20 μl o micropipetas de volumen fijo de 10 μl y puntas
- Sistema de electroforesis en gel (por ejemplo, blueGel™ o GELATO™)
Otros requisitos:
- Agua destilada o desionizada (para disolver el buffer TBE)
*Imagen referencial